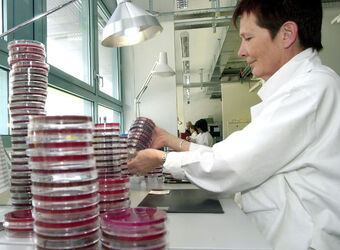
Bellinzona laboratorio cantonale inaugurazione Bellinzona laboratorio cantonale inaugurazione

titoloBellinzona: laboratorio cantonale inaugurazione
credito#
authorSamuel Golay
categorianews
data soggetto17-03-2003
2484517-03-2003
nome file03078sgz.jpg
titoloBellinzona: laboratorio cantonale inaugurazione
luogoBellinzona
credito
17.03.2003 - Bellinzona\, inaugurazione della nuova sede del Laboratorio Cantonale e dell' Istituto Cantonale di Microbiologia. Nella foto, una ricercatrice al lavoro. Digitalfoto Ti-Press/ Samuel Golay 2003

2483117-03-2003
nome file03078sgr.jpg
titoloBellinzona: laboratorio cantonale inaugurazione
luogoBellinzona
credito
17.03.2003 - Bellinzona\, inaugurazione della nuova sede del Laboratorio Cantonale e dell' Istituto Cantonale di Microbiologia. Nella foto, Mario Jaeggli (Direttore del Laboratorio Cantonale). Digitalfoto Ti-Press/ Samuel Golay 2003

2479017-03-2003
nome file03078sgq.jpg
titoloBellinzona: laboratorio cantonale inaugurazione
luogoBellinzona
credito
17.03.2003 - Bellinzona\, inaugurazione della nuova sede del Laboratorio Cantonale e dell' Istituto Cantonale di Microbiologia. Nella foto, una ricercatrice al lavoro. Digitalfoto Ti-Press/ Samuel Golay 2003

2475417-03-2003
nome file03078sgn.jpg
titoloBellinzona: laboratorio cantonale inaugurazione
luogoBellinzona
credito
17.03.2003 - Bellinzona\, inaugurazione della nuova sede del Laboratorio Cantonale e dell'Istituto cantonale di Microbiologia. Nella foto l'esterno del nuovo centro che comprende il laboratorio Cantonale e l'Istituto di Microbiologia. Digitalfoto Ti-Press / Samuel Golay 2003

2469117-03-2003
nome file03078sgj.jpg
titoloBellinzona: laboratorio cantonale inaugurazione
luogoBellinzona
credito
17.03.2003 - Bellinzona\, inaugurazione della nuova sede del Laboratorio Cantonale e dell' Istituto Cantonale di Microbiologia. Nella foto, una ricercatrice al lavoro. Digitalfoto Ti-Press/ Samuel Golay 2003

2445317-03-2003
nome file03078sgu.jpg
titoloBellinzona: laboratorio cantonale inaugurazione
luogoBellinzona
credito
17.03.2003 - Bellinzona\, inaugurazione della nuova sede del Laboratorio Cantonale e dell' Istituto Cantonale di Microbiologia. Nella foto, Giovanni Petazzi (coordinatore dipartimentale e Direttore Divisione Salute Pubblica) durante la conferenza di presentazione. Digitalfoto Ti-Press/ Samuel Golay 2003

2433017-03-2003
nome file03078sgm.jpg
titoloBellinzona: laboratorio cantonale inaugurazione
luogoBellinzona
credito
17.03.2003 - Bellinzona\, inaugurazione della nuova sede del Laboratorio Cantonale e dell'Istituto cantonale di Microbiologia. Nella foto l'esterno del nuovo centro che comprende il laboratorio Cantonale e l'Istituto di Microbiologia. Digitalfoto Ti-Press / Samuel Golay 2003

2411617-03-2003
nome file03078sgg.jpg
titoloBellinzona: laboratorio cantonale inaugurazione
luogoBellinzona
credito
17.03.2003 - Bellinzona\, inaugurazione della nuova sede del Laboratorio Cantonale e dell' Istituto Cantonale di Microbiologia. Nella foto, Thomas Zeltner Direttore dell'ufficio Federale della Sanità Pubblica, durante l' inaugurazione. Digitalfoto Ti-Press/ Samuel Golay 2003

2392817-03-2003
nome file03078sgy.jpg
titoloBellinzona: laboratorio cantonale inaugurazione
luogoBellinzona
credito
17.03.2003 - Bellinzona\, inaugurazione della nuova sede del Laboratorio Cantonale e dell'Istituto cantonale di Microbiologia. Nella foto da sinistra, Mario Jaeggli (Direttore del Laboratorio Cantonale) e Raffaele Peduzzi (Direttore dell' Istituto Cantonale di icrobiologia), all' interno di uno dei nuovi laboratori. Digitalfoto Ti-Press / Samuel Golay 2003

2372917-03-2003
nome file03078sgl.jpg
titoloBellinzona: laboratorio cantonale inaugurazione
luogoBellinzona
credito
17.03.2003 - Bellinzona\, inaugurazione della nuova sede del Laboratorio Cantonale e dell' Istituto Cantonale di Microbiologia. Nella foto da sinistra, Mario Jaeggli (Direttore del Laboratorio Cantonale) Raffaele Peduzzi (Direttore dell' Istituto di Microbiologia) e Patrizia Pesenti (consigliere di Stato), mentre osservano il lavoro di una ricercatrice tra i nuovi laboratori di Bellinzona. Digitalfoto Ti-Press/ Samuel Golay 2003

2362817-03-2003
nome file03078sgo.jpg
titoloBellinzona: laboratorio cantonale inaugurazione
luogoBellinzona
credito
17.03.2003 - Bellinzona\, inaugurazione della nuova sede del Laboratorio Cantonale e dell' Istituto Cantonale di Microbiologia. Nella foto da sinistra, Raffaele Peduzzi (Direttore dell' Istituto di Microbiologia) e Patrizia Pesenti (consigliere di Stato), all'interno dei nuovi laboratori di Bellinzona. Digitalfoto Ti-Press/ Samuel Golay 2003

2360117-03-2003
nome file03078sgi.jpg
titoloBellinzona: laboratorio cantonale inaugurazione
luogoBellinzona
credito
17.03.2003 - Bellinzona\, inaugurazione della nuova sede del Laboratorio Cantonale e dell' Istituto Cantonale di Microbiologia. Nella foto, Mario Jaeggli (Direttore del Laboratorio Cantonale). Digitalfoto Ti-Press/ Samuel Golay 2003

2341517-03-2003
nome file03078sgh.jpg
titoloBellinzona: laboratorio cantonale inaugurazione
luogoBellinzona
credito
17.03.2003 - Bellinzona\, inaugurazione della nuova sede del Laboratorio Cantonale e dell' Istituto Cantonale di Microbiologia. Nella foto, Thomas Zeltner Direttore dell'ufficio Federale della Sanità Pubblica, durante l' inaugurazione. Digitalfoto Ti-Press/ Samuel Golay 2003

2331817-03-2003
nome file03078sgk.jpg
titoloBellinzona: laboratorio cantonale inaugurazione
luogoBellinzona
credito

